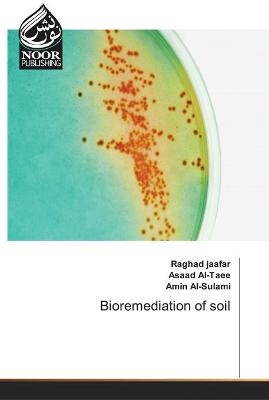
Bioremediation of soil - Raghad Jaafar, Asaad Al-Taee, Amin Al-Sulami

Bioremediation of soil
Seiten
2019
Noor Publishing (Verlag)
978-613-9-42993-6 (ISBN)
Noor Publishing (Verlag)
978-613-9-42993-6 (ISBN)
- Keine Verlagsinformationen verfügbar
- Artikel merken
This book contain different studies in bioremediation of heavy metals using different species of bacteria which isolated from soil of Basra city south of Iraq. these bacteria showed excellent bioremediation ability through two routes, bioaccumulation and biosoption which in turn emphasis using advance technique such as TEM, FTIR, and , XRD. Finally from the results we can recommended to use these bacteria in remediate heavy metals in situ after increase their biomass using bioreactor.
| Erscheinungsdatum | 06.05.2019 |
|---|---|
| Sprache | englisch |
| Maße | 152 x 229 mm |
| Gewicht | 92 g |
| Themenwelt | Naturwissenschaften ► Biologie ► Allgemeines / Lexika |
| Naturwissenschaften ► Biologie ► Mikrobiologie / Immunologie | |
| Schlagworte | Bacteria • bioremediation • Heavy metals • Soil |
| ISBN-10 | 613-9-42993-5 / 6139429935 |
| ISBN-13 | 978-613-9-42993-6 / 9786139429936 |
| Zustand | Neuware |
| Informationen gemäß Produktsicherheitsverordnung (GPSR) | |
| Haben Sie eine Frage zum Produkt? |
Mehr entdecken
aus dem Bereich
aus dem Bereich
Buch | Softcover (2024)
Wiley-VCH (Verlag)
CHF 55,85
Band 2: Elektrizität, Optik und Wellen
Buch | Softcover (2022)
Wiley-VCH (Verlag)
CHF 55,85
Vom Ursprung der Sexualitat zum modernen Menschen
Buch | Softcover (2025)
UTB (Verlag)
CHF 54,60


